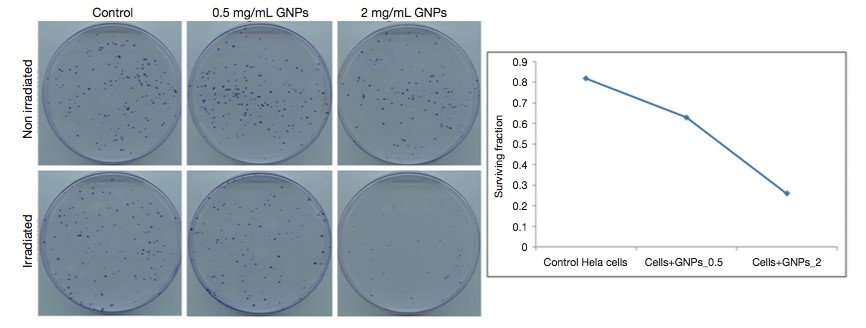

When treating tumors, it is essential to maximize the treatment’s effect on the cancer cells and to minimize the residual effects on the normal, surrounding tissue. For radiation, a regionally specified yet very damaging treatment, it is believed that the use of high-Z nanoparticles can enhance the radiation effect on the tumor, which could ultimately minimize the total amount of radiation the patient is exposed to. When high-Z nanoparticles, such as gold or gadolinium, are exposed to radiation, the x-rays cause electrons to be emitted from the nanoparticles through the Auger effect. The emission of these Auger electrons is destructive to the cancer cells, which, in addition to the x-ray itself, kills more of the tumor. This in vitro investigation will analyze the effect of gold nanoparticles, gold clusters, and gadolinium nanoparticles on cancer cell lines when treated with radiation. The cell lines Capan-1, A549 and HUVEC will be tested with these various nanoparticles. The effect of two different types of radiation, high and low energy beams, will be used to observe efficacy. This in vitro experiment is meant to test the overall effect of high-Z nanoparticles in combination with radiation treatment.